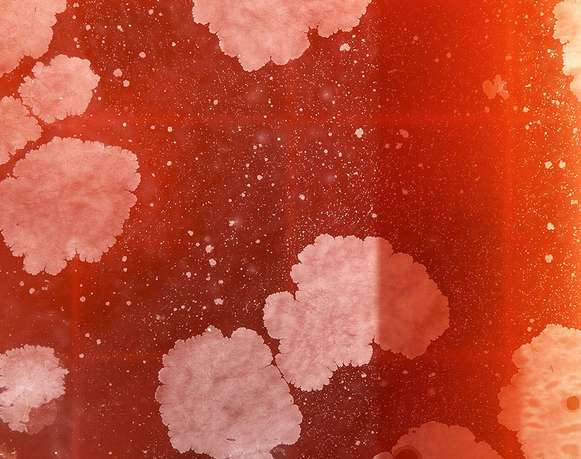
Karla Leyva

Casa Equis es un espacio de arte autogestionado por los artistas Diego Beyró y Carleti Lopez Traviesa. Casa Equis es una fusión entre un espacio independiente y una galería de arte tradicional. La galería trabaja principalmente con artistas jóvenes y representa obras por periodos de tiempo limitado. En sus primeros dos años han realizado numerosas exposiciones dentro y fuera de la galería colaborando curadores y otros espacios. Cuenta actualmente con una tienda online y un showroom en un departamento habitacional al frente del Museo del Chopo.
Dr Enrique González Martinez 7, interior 12, tercer piso (edificio con rejas negras).
Los sábados de 2 a 7pm o por cita (agendar por DM)
Exposiciones y eventos pasados
_2_53_37%E2%80%AFp_m__581x459_thumb.png?alt=media&token=13896233-bf29-473d-a23c-13597efae7a3)
Gilda Medina
Cierre
-> 4 may 2024
_581x459_thumb.jpg?alt=media&token=49fd634c-eeea-4d5f-9903-cdf030b4fc6d)
El color y la pintura en la práctica de Gilda Medina y Alma Camelia
Plática
-> 26 abr

Gilda Medina
Exposición
-> 6 abr 2024 – 4 may 2024

Diana Bama
Cierre
-> 30 mar 2024

Diana Bama
Visita guiada
-> 16 mar 2024

Diana Bama
Exposición
-> 16 feb 2024 – 16 mar 2024

Carleti López Traviesa
Visita guiada
-> 8 feb 2024

Carleti López Traviesa
Exposición
-> 28 ene 2024 – 10 feb 2024

Chiquititas
Exposición
-> 15 dic 2023 – 13 ene 2024

Melissa Paredes
Pop Up
-> 18 nov 2023 – 19 nov 2023

Pablo Delgado
Exposición
-> 4 nov 2023 – 25 nov 2023

Iram de la Rochefoucault
Exposición
-> 22 sep 2023 – 21 oct 2023

Misa Barajas
Exposición
-> 11 ago 2023 – 23 sep 2023

Fernanda Uski
Exposición
-> 30 jun 2023 – 5 ago 2023

Fabiana Comas
Cierre
-> 24 jun 2023

Fabiana Comas
Exposición
-> 26 may 2023 – 24 jun 2023

Antoine de Pins
Cierre
-> 20 may 2023

Antoine de Pins
Exposición
-> 15 abr 2023 – 20 may 2023

Carmen Serratos
Exposición
-> 4 feb 2023 – 25 feb 2023

Empezando bien
Exposición
-> 14 ene 2023 – 21 ene 2023

Carleti López Traviesa
Visita guiada
-> 17 dic 2022

Carleti López Traviesa
Exposición
-> 26 nov 2022 – 14 ene 2023

Benjamin Torres
Cierre
-> 19 nov 2022

Benjamín Torres
Exposición
-> 19 oct 2022 – 19 nov 2022

Melissa Paredes
Cierre
-> 15 oct 2022

Melissa Paredes
Exposición
-> 21 sep 2022 – 15 oct 2022

Sebastián Fonnegra
Cierre
-> 17 sep 2022

Kelsey Shwetz
Exposición
-> 25 mar 2021 – 18 abr 2021

Vendida
Exposición
-> 11 mar 2021 – 4 abr 2021

Erick De Gorostegui
Exposición
-> 25 feb 2021 – 21 mar 2021

Corinne Thiessen
Exposición
-> 11 feb 2021 – 7 mar 2021

Pedro Trueba Ramírez
Exposición
-> 28 ene 2021 – 21 feb 2021

Santiago Mora
Exposición
-> 14 ene 2021 – 9 feb 2021

Luciana Ponte
Exposición
-> 10 dic 2020 – 31 ene 2021

Incendiarias
Exposición
-> 5 dic 2020 – 1 feb 2021

Cuatro en la mano
Exposición
-> 14 nov 2020 – 15 nov 2020

Matthew Anderson
Exposición
-> 7 nov 2020 – 6 dic 2020

Eliana Portilla
Exposición
-> 17 oct 2020 – 15 nov 2020

Fernanda Carri
Exposición
-> 3 oct 2020 – 28 oct 2020

Emilio Lameiras
Exposición
-> 19 sep 2020 – 14 oct 2020

Carleti López Traviesa
Exposición
-> 5 sep 2020 – 30 sep 2020

Luis Rochin
Exposición
-> 22 ago 2020 – 16 sep 2020

Samara Colina
Exposición
-> 8 ago 2020 – 2 sep 2020

Jorge Rosano Gamboa
Exposición
-> 25 jul 2020 – 19 ago 2020

Todo Foto
Exposición
-> 11 jul 2020 – 24 jul 2020

Arantxa Solis
Exposición
-> 27 jun 2020 – 10 jul 2020

Píxeles activados
Exposición
-> 13 jun 2020 – 4 jul 2020

Ivan Krassoievitch
Exposición
-> 6 jun 2020 – 27 jun 2020

Virtuoso virtual
Exposición
-> 23 may 2020 – 1 jun 2020

Feria de cerámica
Feria de arte
-> 15 mar 2020

Exposiciones marzo
Exposición
-> 5 mar 2020 – 29 mar 2020

Fabián Ramírez y Omar Mendoza
Exposición
-> 20 feb 2020 – 1 mar 2020

Guillermo Santamarina | Saelia Aparicio y Anousha Payne | Héctor Madera
Exposición
-> 5 feb 2020 – 1 mar 2020

Alexis Cruces | Miguel Casco | Sebastián Fonnegra | Jessi Rapp
Exposición
-> 16 ene 2020 – 2 feb 2020

Venta especial de menos de MXN 2000
Feria de arte
-> 21 dic 2019 – 22 dic 2019

Nina Fiocco | Eloísa Hardy | Sebastián Fonegra | joshua jobb - irak morales
Exposición
-> 5 dic 2019 – 5 ene 2020

Cierre de exposiciones de noviembre
Cierre
-> 24 nov 2019

El sonido y el sistema solar por Stefana Fratila
Plática
-> 22 nov 2019

Tandemmm | Misa Barajas | Beth Frey | Montserrat Ayala
Exposición
-> 2 nov 2019 – 24 nov 2019

Nicole Chaput y Ana Segovia
Plática
-> 19 oct 2019

Nicole Chaput
Exposición
-> 12 oct 2019 – 20 oct 2019

Malteada la vida
Exposición
-> 3 oct 2019 – 6 oct 2019

FIFA2000
Exposición
-> 26 sep 2019 – 29 sep 2019
Karla Leyva
Exposición
-> 19 sep 2019 – 22 sep 2019

Alejandro Romero
Exposición
-> 13 sep 2019 – 15 sep 2019

Nicole Chaput, Gina Mier, Claire Price
Exposición
-> 5 sep 2019 – 8 sep 2019

Alicia Ayanegui
Exposición
-> 29 ago 2019 – 1 sep 2019